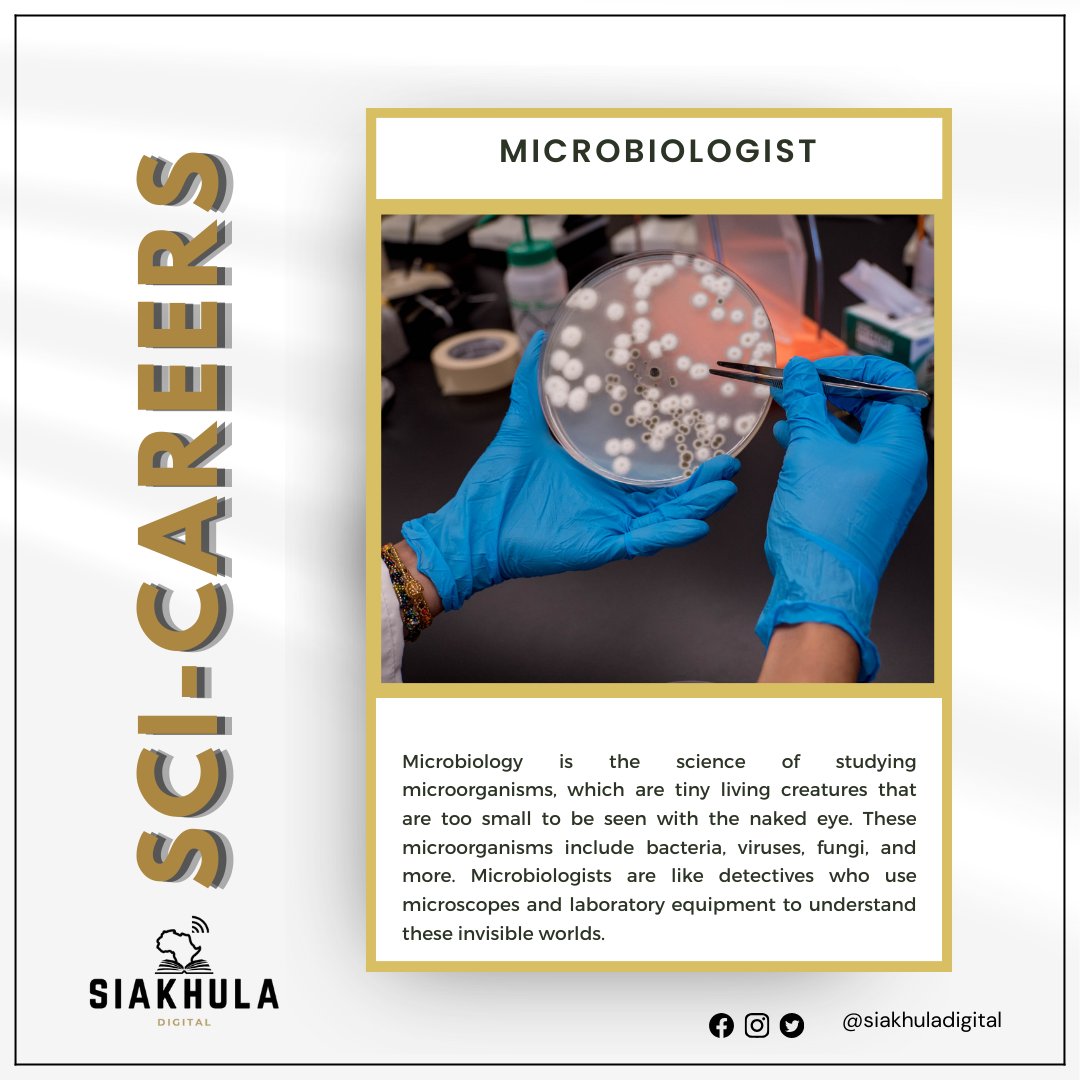
It's #TuesACareerDay, and we're zooming in on Microbiology! 🦠 Curious about the tiny world of microorganisms? Explore the secrets of this fascinating field and discover why it's a path filled with endless opportunities! 🔬🌍 #Microbiology #ScienceCareer

SIAkhula Digital
@siakhuladigital
We do marketing for scientists!
Scicomm training & consultancy
ID: 1433276927612231680
https://linktr.ee/SiakhulaDigital 02-09-2021 03:54:44
278 Tweet
120 Takipçi
279 Takip Edilen

Curious about the power of scientific communication? Science isn't just for the experts; it's for everyone. Siakhula Digital is here to help you on this exciting journey! Let's make science accessible and impactful. Reach out to us today [email protected] 🔬🌍